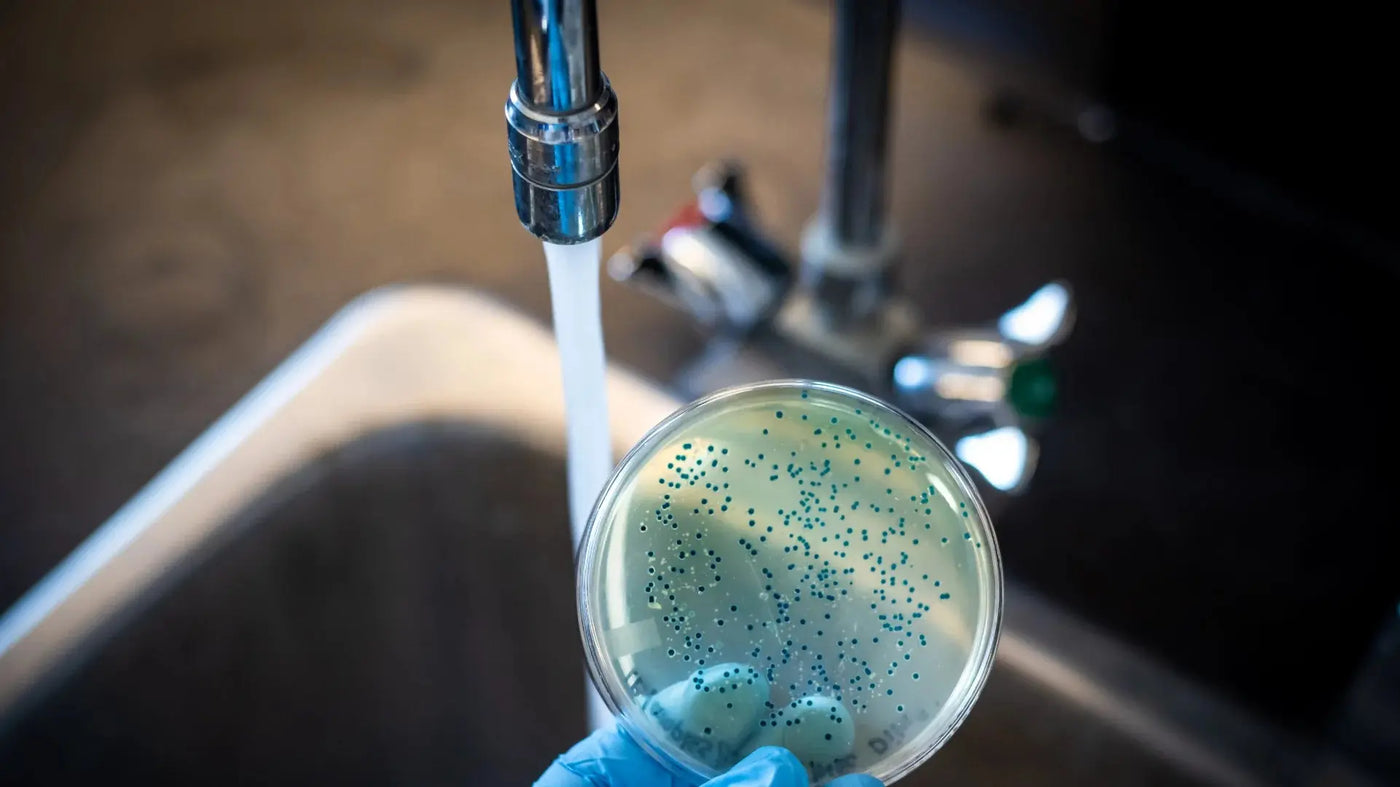

Life Sciences Water Blog

Unlocking the Secrets: Safeguard Your Family from Iron Contami...
Iron Contamination: A Silent Threat Affecting Millions of Americans Iron Contamination Awareness: A Crucial Step Towards Healthier L...
Read More
Nitrates in Your Drinking Water: Sources, Health Effects, and ...
Nitrate contamination in drinking water is a matter of significant concern, particularly for vulnerable individuals such as pregnant...
Read More
Mercury in Seafood and Drinking Water: A Dual Threat to Human ...
Mercury, a toxic heavy metal, has been a subject of concern due to its adverse impact on both the environmental and human health. WH...
Read More
Exploring Cadmium in U.S. Drinking Water: Health Implications,...
Cadmium, a naturally occurring metallic element, has been discovered in various products and substances, raising potential health co...
Read More
Hexavalent Chromium Contamination in Tap Water: Health Hazards...
Industrial health and safety is built on knowledge. Hexavalent Chromium (Cr(VI)), a highly toxic compound commonly found in industri...
Read More
The Microplastic Epidemic: How Far has it Infiltrates Our Live...
In a world where convenience prevails, the emergence of microplastics is an alarming concern. These minuscule plastic particles, sma...
Read More
New Approach to Water Treatment: Our Reverse Osmosis Systems R...
In an era where water quality is paramount, our advanced Reverse Osmosis (RO) systems stand as a beacon of hope. These systems have ...
Read More
Take a Look at the Health Benefits of Hydrogen Water and Alkal...
Introduction In recent years, the health and wellness industry has been abuzz with the incredible potential of hydrogen water, also ...
Read More
How Do Alkaline Water Systems Affect Your Stomach pH AND Gastr...
When it comes to alkaline Mineral water and its impact on stomach acidity, there are often questions and misconceptions. You might w...
Read More
The Impact of pH Balance on Kidney Function: How Alkaline Mine...
The term "detox" is often used to describe a need for a lifestyle change. Whether recommended by a professional, prompted by a lack ...
Read More
Uric Acid Control Through Alkaline Mineral Water: A Natural Ap...
Gout, a chronic form of inflammatory arthritis, often stems from elevated uric acid levels in the body. The painful consequences inc...
Read More
How Does Alkaline Mineralized Water Impact Gut Microbes and We...
In the pursuit of a healthy lifestyle and effective weight management, many individuals focus primarily on diet and exercise, often ...
Read More
Discover LifeSciencesWater: Elevate Your Hydration Experience
Are you seeking the ultimate solution to supercharge your hydration and boost your overall health? Look no further than LifeSciences...
Read More
Is Ionized Alkaline Water the Key to 40+ Health Benefits and a...
Over half of all American adults, and an increasing number of youth, are struggling with immune system dysfunction. In today's fast-...
Read More
Dr. Emoto's Visionary Research: Can the Flower of Life Tru...
Dr. Masaru Emoto, a Japanese author and researcher, gained worldwide attention for his controversial studies on how human consciousn...
Read More
Free Water Quality Report and Analysis: Unveiling the Truth Be...
It's easy to take for granted the water that flows from our taps, assuming its purity and safety. Most people rely on the EPA's city...
Read More
Copper water bottles for healthy drinking
A study by the University of South Carolina reported that copper killed 97% of unwanted contaminants in ICUs, reducing the risk of h...
Read More
What do Activated Carbon Block filters remove and reduce?
Water filters that use activated carbon blocks are one of the top 3 choices. This is because they are capable of effectively removin...
Read More
What filter removes Fluoride?
ACTIVATED ALUMINA Activated alumina (AA) is the only filter material specifically designed to remove fluoride and arsenic from water...
Read More
Alkaline Water can help you DETOX from 10 Different Heavy Metals
If you are concerned about heavy metals and other contaminants in your body (you should be) you can detox from them with healthy alk...
Read More
How do you live to be over 100?
Alkaline water can help you detoxify and improve your healthAlkaline Water BenefitsDid you know this fact? The largest study ever co...
Read More
What you can do to protect yourself from heavy metals in drink...
Get Your Free Water Quality ReportWe can extract the data from your local water report and generate a report letting you know what c...
Read More
30,000 Pounds of Toxic Chemicals, per person, in the US
The facts and information here will provide the information and knowledge that will turn your fear into anger. Fear is an emotion th...
Read More
Can Drinking Water be Harmful?
The answer is: What’s in the water? Effects on Human Health If the water you are drinking contains unsafe levels, or even any lev...
Read More
What Contaminants are in my Water?
This is one of the most asked questions! And the scary thing is that all these dangerous contaminants can also be in any prepared ...
Read More
What are Drinking Water Contaminants?
This is scary…so read and understand that you must protect yourself and your Family! The Environmental Protection Agency (EPA) regul...
Read More
Senior Man Suffering and Having Chest Pain
The 5 symptoms of heart attacks found by the Centers for Disease Control Chest Pain is the most common system found: Each day we wil...
Read More